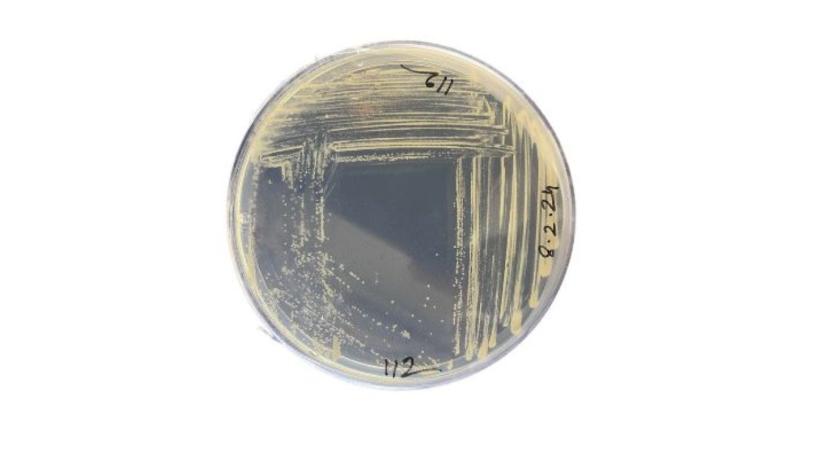
Új, szén-monoxid-lebontásra képes baktériumfajt írtak le a MATE kutatói

Új, szén-monoxid-lebontásra képes baktériumfajt írtak le a MATE kutatói
A University of Warwick, a Magyar Agrár- és Élettudományi Egyetem (MATE) és az Eötvös Loránd Tudományegyetem (ELTE) kutatóinak közös munkája során egy eddig ismeretlen baktériumfajt azonosítottak, amely képes a levegőben található szén-monoxid (CO) lebontására. Az új faj a Foliimonas ilicis nevet kapta és az örökzöld magyal (Ilex aquifolium) leveleiről izolálták. Az eredményeket a kutatók az Új, szén-monoxid-lebontásra képes baktériumfajt írtak le a MATE kutatói
- Hirdetés -